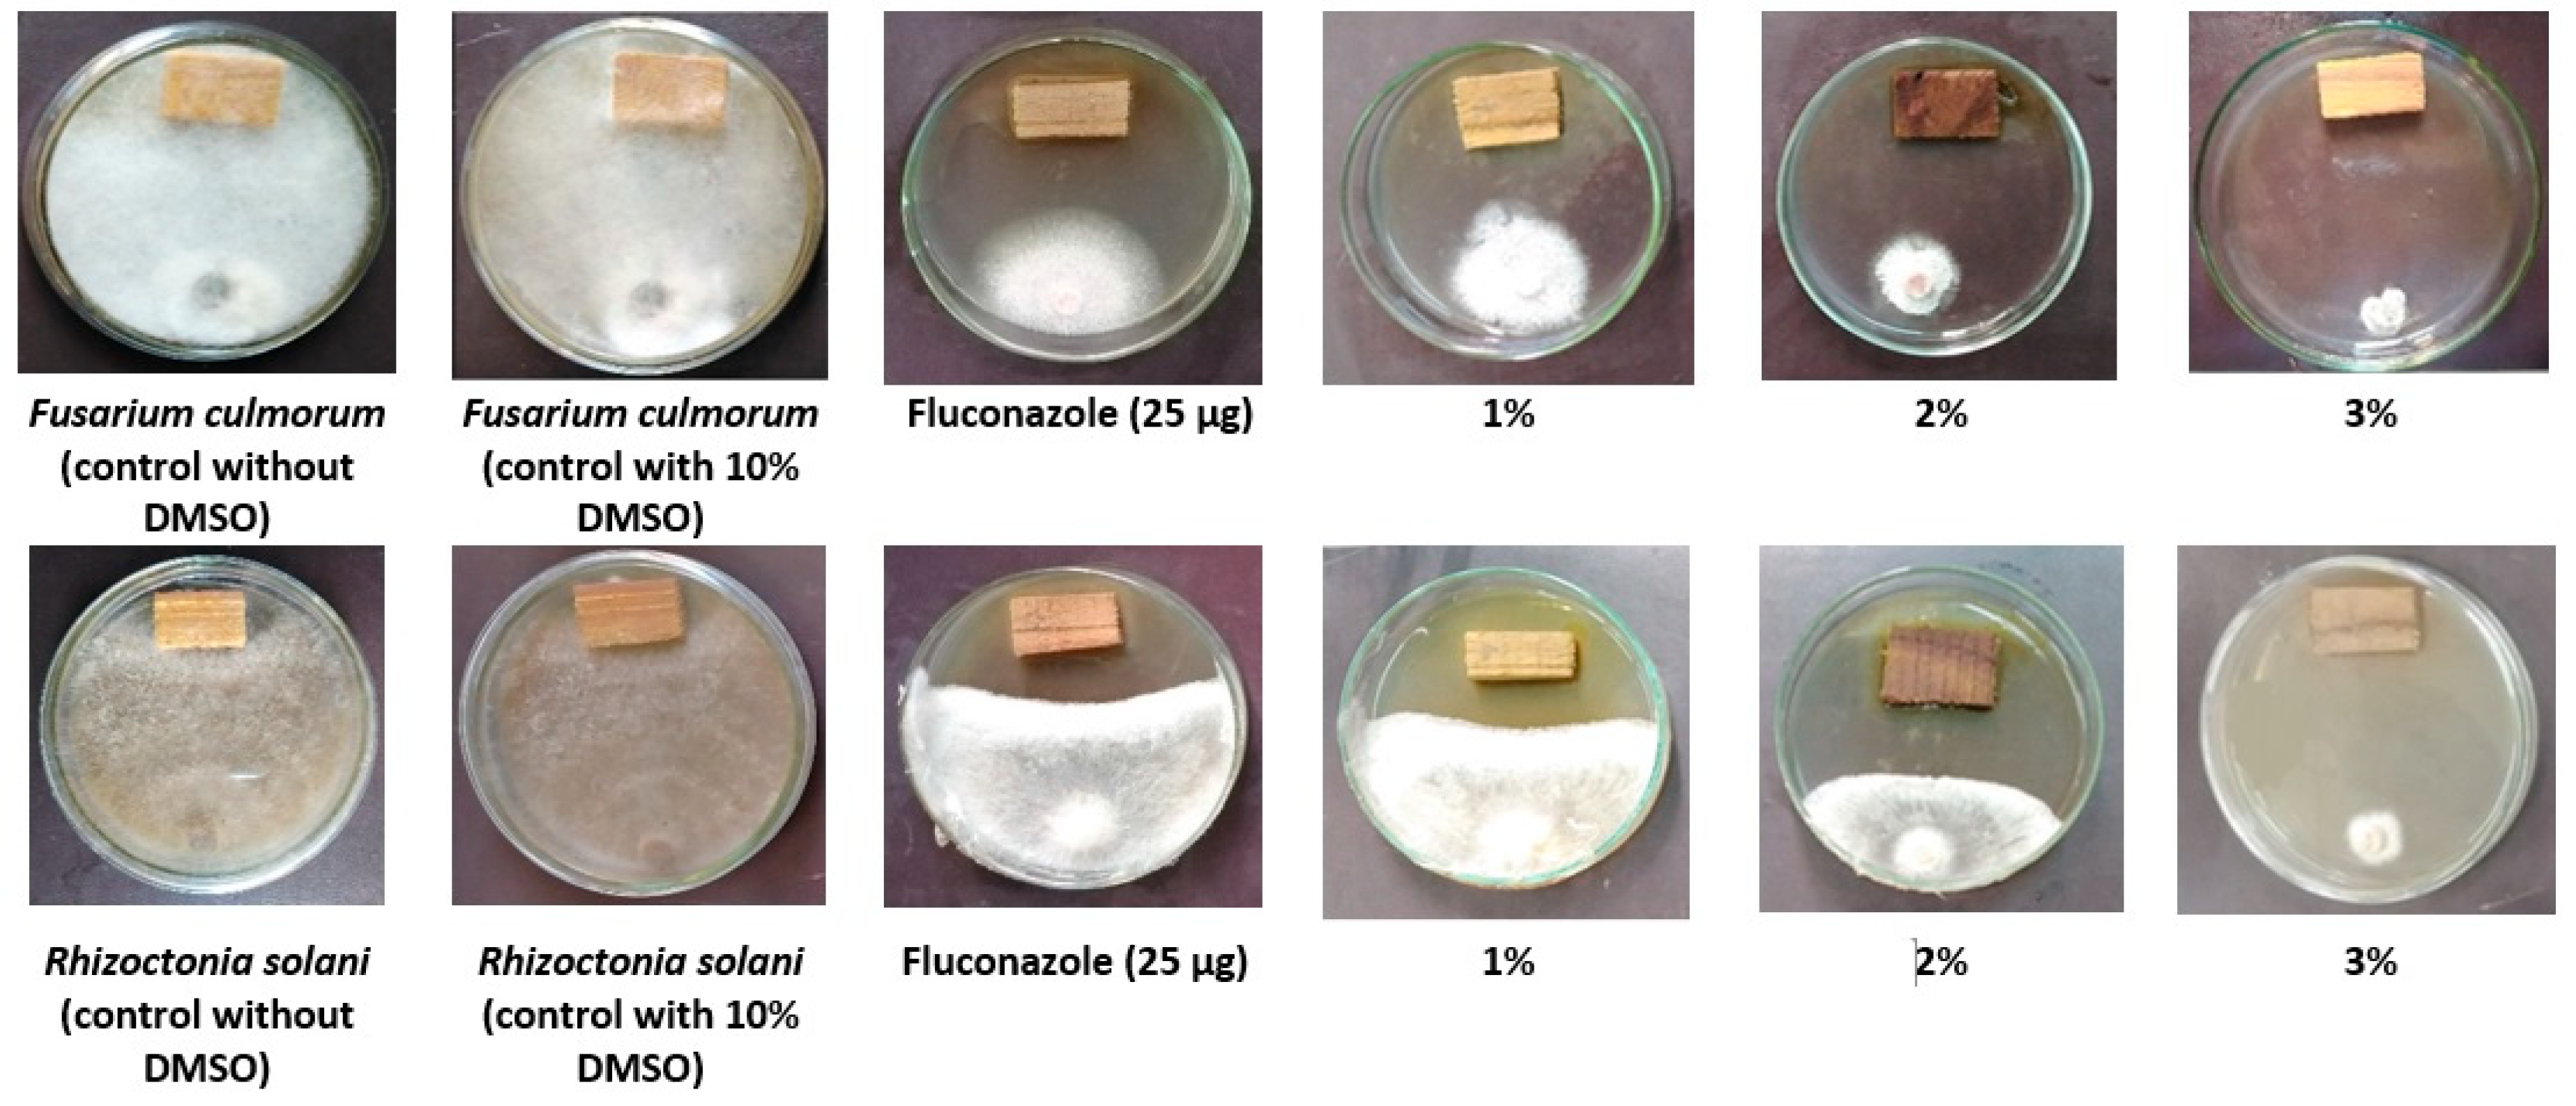
Biology 09 00248 g001

The Phytochemical, Antifungal, and First Report of the Antiviral Properties of Egyptian Haplophyllum tuberculatum Extract
Abstract
:1. Introduction
2. Materials and Methods
2.1. Preparation of the H. tuberculatum Extract and HPLC Analysis of Phenolic Compounds
2.2. Antifungal Property of Wood Treated with H. tuberculatum WPE
2.3. Source of Virus, Inoculum Preparation and Antiviral Activity Assays
2.4. Protective and Inactivity of WPE Assays
2.5. Plant Total RNA Extraction and cDNA Synthesis
2.6. Quantitative Real-Time PCR (qPCR) Assay and Data Analysis
2.7. Statistical Analysis
3. Results
3.1. Polyphenolic Compounds in the Ethanol Extract
3.2. Antifungal Property
3.3. Effect of H. tuberculatum WPE on Disease Severity and TMV Accumulation Levels
3.4. Protective Assay: Changes in the Transcriptional Levels of PR-1, CHS, and HQT
3.5. Inactivity Assay: Changes in Transcriptional Levels of PR-1, CHS, and HQT
4. Discussion
5. Conclusions
Author Contributions
Funding
Conflicts of Interest
References
- Al-Muniri, R.M.S.; Hossain, M.A. Evaluation of antioxidant and cytotoxic activities of different extracts of folk medicinal plant Hapllophyllum tuberculatum. Egypt. J. Basic Appl. Sci. 2017, 4, 101–106. [Google Scholar] [CrossRef] [Green Version]
- Abdelkhalek, A.; Ismail, I.A.; Dessoky, E.S.; El-Hallous, E.I.; Hafez, E. A tomato kinesin-like protein is associated with Tobacco mosaic virus infection. Biotechnol. Biotechnol. Equip. 2019, 33, 1424–1433. [Google Scholar] [CrossRef] [Green Version]
- Bazzini, A.A.; Hopp, H.E.; Beachy, R.N.; Asurmendi, S. Infection and coaccumulation of Tobacco mosaic virus proteins alter microRNA levels, correlating with symptom and plant development. Proc. Natl. Acad. Sci. USA 2007, 104, 12157–12162. [Google Scholar] [CrossRef] [Green Version]
- Abdelkhalek, A. Expression of tomato pathogenesis related genes in response to Tobacco mosaic virus. J. Anim. Plant Sci. 2019, 29, 1596–1602. [Google Scholar]
- Scholthof, K.G.; Adkins, S.; Czosnek, H.; Palukaitis, P.; Jacquot, E.; Hohn, T.; Hohn, B.; Saunders, K.; Candresse, T.; Ahlquist, P. Top 10 plant viruses in molecular plant pathology. Mol. Plant Pathol. 2011, 12, 938–954. [Google Scholar] [CrossRef]
- Gao, Q.-M.; Kachroo, A.; Kachroo, P. Chemical inducers of systemic immunity in plants. J. Exp. Bot. 2014, 65, 1849–1855. [Google Scholar] [CrossRef] [Green Version]
- Elsharkawy, M.M.; Shimizu, M.; Takahashi, H.; Ozaki, K.; Hyakumachi, M. Induction of systemic resistance against Cucumber mosaic virus in Arabidopsis thaliana by Trichoderma asperellum SKT-1. Plant Pathol. J. 2013, 29, 193–200. [Google Scholar] [CrossRef] [Green Version]
- Glala, A.A.; Hoda, A.M.; Fawzi, Z.F. Improving tomato plant growth, health, earliness, productivity and fruit quality by chemically induced systematic resistance. J. Appl. Sci. Res. 2005, 1, 362–372. [Google Scholar]
- Hammerschmidt, R. Induced disease resistance: How do induced plants stop pathogens? Physiol. Mol. Plant Pathol. 1999, 55, 77–84. [Google Scholar] [CrossRef]
- Lawton, K.A.; Friedrich, L.; Hunt, M.; Weymann, K.; Delaney, T.; Kessmann, H.; Staub, T.; Ryals, J. Benzothiadiazole induces disease resistance in Arabidopsis by activation of the systemic acquired resistance signal transduction pathway. Plant J. 1996, 10, 71–82. [Google Scholar] [CrossRef]
- Benhamou, N.; Belanger, R. Benzothiazole-mediated induced resistance to Fusarium oxysporum f. sp. radicis in tomato. Plant Physiol. 1998, 118, 1203–1212. [Google Scholar] [CrossRef] [Green Version]
- Šišić, A.; Baćanović, J.; Al-Hatmi, A.M.; Karlovsky, P.; Ahmed, S.A.; Maier, W.; De Hoog, G.S.; Finckh, M.R. The ‘forma specialis’ issue in Fusarium: A case study in Fusarium solani f. sp. pisi. Sci. Rep. 2018, 8, 1252. [Google Scholar]
- Sabuquillo, P.; Cal, A.D.; Melgarejo, P. Biocontrol of tomato wilt by Penicillium oxalicum formulations in different crop conditions. Biol. Control 2006, 37, 256–265. [Google Scholar] [CrossRef]
- Kim, J.; Kim, J.D. Inhibitory effect of algal extracts on mycelial growth of the tomato-wilt pathogen, Fusarium oxysporum f. sp. lycopersici. Mycobiol. 2008, 36, 242–248. [Google Scholar] [CrossRef] [Green Version]
- Al-Huqail, A.A.; Behiry, S.I.; Salem, M.Z.M.; Ali, H.M.; Siddiqui, M.H.; Salem, A.Z.M. Antifungal, antibacterial, and antioxidant activities of Acacia saligna (Labill.) HL Wendl. flower extract: HPLC analysis of phenolic and flavonoid compounds. Molecules 2019, 24, 700. [Google Scholar] [CrossRef] [Green Version]
- Lewis, J.A.; Lumsden, R.D.; Locke, J.C. Biocontrol of damping-off diseases caused by Rhizoctonia solani and Pythium ultimum with alginate prills of Gliocladium virens, Trichoderma hamatum and various food bases. Biocontrol Sci. Technol. 1996, 6, 163–173. [Google Scholar] [CrossRef]
- Fravel, D.; Olivain, C.; Alabouvette, C. Fusarium oxysporum and its biocontrol. New Phytol. 2003, 157, 493–502. [Google Scholar] [CrossRef]
- Hibar, K.; Daami-Remadi, M.; Jabnoun-Khiareddine, H.; El Mahjoub, M. Fusarium crown and root rot and its chemical control. Int. J. Agric. Res. 2007, 2, 687–695. [Google Scholar]
- Dissanayake, M.L.M.C.; Jayasinghe, J.A.N. Antifungal activity of selected medicinal plant extracts against plant pathogen fungi; Rhizoctonia solani, Colletotrichum musea and Fusarium oxysporum. Int. J. Sci. Invent. Today 2013, 2, 421–431. [Google Scholar]
- Kagale, S.; Marimuthu, T.; Nandakumar, R.; Samiyappan, R. Antimicrobial activity and induction of systemic resistance in rice by leaf extract of Datura metel against Rhizoctonia solani and Xanthomonas oryzae pv. Oryzae. Physiol. Mol. Plant Pathol. 2004, 65, 91–100. [Google Scholar] [CrossRef]
- Mahesh, B.; Satish, S. Antimicrobial activity of some important medicinal plant against plant and human pathogens. World J. Agric. Sci. 2008, 4, 839–843. [Google Scholar]
- Raza, W.; Ghazanfar, M.U.; Iftikhar, Y.; Ahmed, K.S.; Haider, N.; Rasheed, M.H. Management of early blight of tomato through the use of plant extracts. Int. J. Zool. Stud. 2016, 1, 1–4. [Google Scholar]
- Bennett, R.N.; Wallsgrove, R.M. Secondary metabolites in plant defense mechanisms. New Phytol. 1994, 127, 617–633. [Google Scholar] [CrossRef]
- Osbourne, A.E. Preformed antimicrobial compounds and plant defense against fungal attack. Plant Cell 1996, 8, 1821–1831. [Google Scholar] [CrossRef]
- Cowan, M.M. Plant products as antimicrobial agents. Clin. Microbiol. Rev. 1999, 12, 564–582. [Google Scholar] [CrossRef] [Green Version]
- Tapwal, A.; Garg, S.; Gautam, N.; Kumar, R. In vitro antifungal potency of plant extracts against five phytopathogens. Braz. Arch. Biol. Technol. 2011, 54, 1093–1098. [Google Scholar] [CrossRef] [Green Version]
- Mengal, A.S.; Hussain, S.; Ali, M.; Abro, M.A.; Jatoi, G.H.; Nisa, N.; Rafiq, M.; Iqbal, S. Evaluation of different botanical extracts on the linear colony growth of the fungus Fusarium wilt of mango nursery and its in-vitro control. Eur. J. Biotechnol. Biosci. 2015, 3, 7–14. [Google Scholar]
- Darmadi, A.A.K.; Suprapta, D.N.; Ginantra, I.K. Effect of cinnamon leaf extract formula (Cinnamomum burmanni Blume) on Fusarium wilt that attacks tomato plants in Bali. Int. J. Pure Appl. Biosci. 2016, 4, 33–38. [Google Scholar] [CrossRef]
- Neela, F.A.; Sonia, I.A.; Shamsi, S. Antifungal activity of selected medicinal plant extract on Fusarium oxysporum Schecht the causal agent of Fusarium wilt disease in tomato. Am. J. Plant Sci. 2014, 5, 2665–2671. [Google Scholar] [CrossRef] [Green Version]
- Abdelkhalek, A.; Hafez, E. Plant viral diseases in Egypt and their control. In Cottage Industry of Biocontrol Agents and Their Applications; Springer: Berlin, Germany, 2020; pp. 403–421. [Google Scholar]
- Jing, B.N.; Ma, Z.Q.; Feng, J.T.; Liang, H.H.Y.; Li, C.; Zhang, X. Evaluation of the antiviral activity of extracts from plants grown in the Qinling Region of China against infection by Tobacco mosaic virus (TMV). J. Phytopathol. 2012, 160, 181–186. [Google Scholar] [CrossRef]
- Shen, J.G.; Wu, Z.J.; Xie, L.H.; Lin, Q.Y. Antiviral effect of medicinal plant extracts on tobacco mosaic virus. Zhong Cao Yao 2006, 37, 259–261. (In Chinese) [Google Scholar]
- Verma, H.; Awasthi, L. Antiviral activity of Boerhaavia diffusa root extract and the physical properties of the virus inhibitor. Can. J. Bot. 1979, 57, 926–932. [Google Scholar] [CrossRef]
- Verma, H.; Kumar, V. Prevention of plant virus diseases by Mirabilis jalapa leaf extract. New Bot. 1980, 7, 87–91. [Google Scholar]
- Jassim, S.A.; Naji, M.A. Novel antiviral agents: A medicinal plant perspective. J. Appl. Microbiol. 2003, 95, 412–427. [Google Scholar] [CrossRef] [Green Version]
- Elbeshehy, E.K.; Metwali, E.M.; Almaghrabi, O.A. Antiviral activity of Thuja orientalis extracts against watermelon mosaic virus (WMV) on Citrullus lanatus. Saudi J. Biol. Sci. 2015, 22, 211–219. [Google Scholar] [CrossRef] [Green Version]
- Waziri, H.M.A. Plants as antiviral agents. J. Plant Pathol. Microb. 2015, 6, 254. [Google Scholar] [CrossRef] [Green Version]
- Mohsen, Z.H.; Jaffer, H.J.; Al-Saad, M.; Ali, Z.S. Insecticidal effects of Haplophyllum tuberculatum against Culex quinquefasciatus. Int. J. Crude Drug Res. 1989, 27, 17–21. [Google Scholar] [CrossRef]
- Onifade, A.K.; Fatope, M.O.; Deadman, M.L.; Al-Kindy, S.M.Z. Nematicidal activity of Haplophyllum tuberculatum and Plectranthuscy lindraceus oils against Meloidogyne javanica. Biochem. Syst. Ecol. 2008, 36, 679–683. [Google Scholar] [CrossRef]
- Al-Burtamani, S.K.S.; Fatope, M.O.; Marwah, R.G.; Onifade, A.K.; Al-Saidi, S.H. Chemical composition, antibacterial and antifungal activities of the essential oil of Haplophyllum tuberculatum from Oman. J. Ethnopharmacol. 2005, 96, 107–112. [Google Scholar] [CrossRef]
- Sheriha, G.M.; Abouamer, K.; Elshtaiwi, B.Z. An alkaloid from Haplophyllum tuberculatum. Phytochemistry 1985, 24, 884–886. [Google Scholar] [CrossRef]
- Hamdi, A.; Viane, J.; Mahjoub, M.A.; Majouli, K.; Gad, M.H.H.; Kharbach, M.; Demeyer, K.; Marzouk, Z.; Vander Heyden, Y. Polyphenolic contents, antioxidant activities and UPLC–ESI–MS analysis of Haplophyllum tuberculatum A. Juss leaves extracts. Int. J. Biol. Macromol. 2018, 106, 1071–1079. [Google Scholar] [CrossRef]
- Hamdi, A.; Majouli, K.; Flamini, G.; Marzouk, B.; Marzouk, Z.; Heyden, Y.V. Antioxidant and anticandidal activities of the Tunisian Haplophyllum tuberculatum (Forssk.) A. Juss. essential oils. S. Afr. J. Bot. 2017, 112, 210–214. [Google Scholar] [CrossRef]
- Salem, M.Z.M.; Mansour, M.M.A.; Elansary, H.O. Evaluation of the effect of inner and outer bark extracts of Sugar Maple (Acer saccharum var. saccharum) in combination with citric acid against the growth of three common molds. J. Wood Chem. Technol. 2019, 39, 136–147. [Google Scholar] [CrossRef]
- Behiry, S.I.; Okla, M.K.; Alamri, S.A.; EL-Hefny, M.; Salem, M.Z.M.; Alaraidh, I.A.; Ali, H.M.; Al-Ghtani, S.M.; Monroy, J.C.; Salem, A.Z.M. Antifungal and antibacterial activities of Musa paradisiaca L. peel extract: HPLC analysis of phenolic and flavonoid contents. Processes 2019, 7, 215. [Google Scholar] [CrossRef] [Green Version]
- Salem, M.Z.M.; Ibrahim, I.H.M.; Ali, H.M.; Helmy, H.M. Assessment the using of natural extracted dyes and pancreatin enzyme for dyeing of four natural textiles: HPLC analysis of phytochemicals. Processes 2020, 8, 59. [Google Scholar] [CrossRef] [Green Version]
- Abdelkhalek, A.; Salem, M.Z.M.; Kordy, A.M.; Salem, A.Z.M.; Behiry, S.I. Antiviral, antifungal, and insecticidal activities of Eucalyptus bark extract: HPLC analysis of polyphenolic compounds. Microb. Pathog. 2020, 147, 104383. [Google Scholar] [CrossRef]
- Ashmawy, N.A.; Salem, M.Z.M.; El Shanhorey, N.; Al-Huqail, A.; Ali, H.M.; Behiry, S.I. Eco-friendly wood-biofungicidal and antibacterial activities of various Coccoloba uvifera L. Leaf Extracts: HPLC analysis of phenolic and flavonoid compounds. BioResources 2020, 15, 4165–4187. [Google Scholar]
- Behiry, S.I.; Nasser, R.A.; Abd El-Kareem, M.S.M.; Ali, H.M.; Salem, M.Z.M. Mass spectroscopic analysis, MNDO quantum chemical studies and antifungal activity of essential and recovered oil constituents of lemon-scented gum against three common molds. Processes 2020, 8, 275. [Google Scholar] [CrossRef] [Green Version]
- Salem, M.Z.M.; Behiry, S.I.; EL-Hefny, M. Inhibition of Fusarium culmorum, Penicillium chrysogenum and Rhizoctonia solani by n-hexane extracts of three plant species as a wood-treated oil fungicide. J. Appl. Microbiol. 2019, 126, 1683–1699. [Google Scholar] [CrossRef]
- EL-Hefny, M.; Salem, M.Z.M.; Behiry, S.I.; Ali, H.M. The potential antibacterial and antifungal activities of wood treated with Withania somnifera fruit extract, and the phenolic, caffeine and flavonoid composition of the extract according to HPLC. Processes 2020, 8, 113. [Google Scholar] [CrossRef] [Green Version]
- Gooding, G.V.J.; Hebert, T.T. A simple technique for purification of tobacco mosaic virus in large quantities. Phytopathology 1967, 57, 1285–1287. [Google Scholar]
- Kubo, S.; Ikeda, T.; Imaizumi, S.; Takanami, Y.; Mikami, Y. A potent plant virus inhibitor found in Mirabilis jalapa L. Ann. Phytopathol. Soc. Jpn. 1990, 56, 481–487. [Google Scholar] [CrossRef]
- Hafez, E.E.; El-Morsi, A.A.; El-Shahaby, O.A.; Abdelkhalek, A.A. Occurrence of Iris yellow spot virus from onion crops in Egypt. Virus Dis. 2014, 25, 455–459. [Google Scholar] [CrossRef] [Green Version]
- Abdelkhalek, A.; Sanan-Mishra, N. Differential expression profiles of tomato miRNAs induced by Tobacco mosaic virus. J. Agric. Sci. Technol. 2019, 21, 475–485. [Google Scholar]
- Abdelkhalek, A.; Al-Askar, A. Green synthesized ZnO nanoparticles mediated by Mentha Spicata extract induce plant systemic resistance against Tobacco mosaic virus. Appl. Sci. 2020, 10, 5054. [Google Scholar] [CrossRef]
- Abdelkhalek, A.; ElMorsi, A.; AlShehaby, O.; Sanan-Mishra, N.; Hafez, E. Identification of genes differentially expressed in Iris yellow spot virus infected onion. Phytopathol. Mediterr. 2018, 57, 334–340. [Google Scholar]
- ElMorsi, A.; Abdelkhalek, A.; AlShehaby, O.; Hafez, E. Pathogenesis-related genes as tools for discovering the response of onion defence system against Iris yellow spot virus infection. Botany 2015, 93, 735–744. [Google Scholar] [CrossRef]
- Abdelkhalek, A.; Al-Askar, A.A.; Hafez, E. Differential induction and suppression of the potato innate immune system in response to Alfalfa mosaic virus infection. Physiol. Mol. Plant Pathol. 2020, 110, 101485. [Google Scholar] [CrossRef]
- Livak, K.J.; Schmittgen, T.D. Analysis of relative gene expression data using real-time quantitative PCR and the 2(-Delta Delta C(T)) method. Methods 2001, 25, 402–408. [Google Scholar] [CrossRef] [PubMed]
- Kavroulakis, N.; Papadopoulou, K.K.; Ntougias, S.; Zervakis, G.I.; Ehaliotis, C. Cytological and other aspects of pathogenesis-related gene expression in tomato plants grown on a suppressive compost. Ann. Bot. 2006, 98, 555–564. [Google Scholar] [CrossRef] [PubMed] [Green Version]
- André, C.M.; Schafleitner, R.; Legay, S.; Lefèvre, I.; Aliaga, C.A.A.; Nomberto, G.; Hoffmann, L.; Hausman, J.-F.; Larondelle, Y.; Evers, D. Gene expression changes related to the production of phenolic compounds in potato tubers grown under drought stress. Phytochemistry 2009, 70, 1107–1116. [Google Scholar] [CrossRef] [PubMed]
- Pasumarthy, K.K.; Mukherjee, S.K.; Choudhury, N.R. The presence of tomato leaf curl Kerala virus AC3 protein enhances viral DNA replication and modulates virus induced gene-silencing mechanism in tomato plants. Virol. J. 2011, 8, 178. [Google Scholar] [CrossRef] [PubMed] [Green Version]
- Zhao, L.; Dong, J.; Hu, Z.; Li, S.; Su, X.; Zhang, J.; Yin, Y.; Xu, T.; Zhang, Z.; Chen, H. Anti-TMV activity and functional mechanisms of two sesquiterpenoids isolated from Tithonia diversifolia. Pestic. Biochem. Physiol. 2017, 140, 24–29. [Google Scholar] [CrossRef] [PubMed]
- SAS. User Guide: Statistics (Release 8.02); SAS Institute: Cary, NC, USA, 2001. [Google Scholar]
- Chaoua, H.; Khacheba, I.; Boussoussa, H.; Bekhaoua, A.; Yousfi, M. A Potent in Vitro α-Amylase Inhibitory Action of Haplophyllum tuberculatum Extracts. Curr. Enzym. Inhib. 2019, 15, 190–196. [Google Scholar] [CrossRef]
- Eissa, T.F.; González-Burgos, E.; Carretero, M.E.; Gómez-Serranillos, M.P. Biological activity of HPLC-characterized ethanol extract from the aerial parts of Haplophyllum tuberculatum. Pharm. Biol. 2014, 52, 151–156. [Google Scholar] [CrossRef]
- Aziza, S.B.; Hebbatallah, A.A.; Maha, A.H.; Shah, A.K. Evaluation of antioxidant potential, total phenolic content and phytochemical screening of aerial parts of a folkloric medicine. Haplophyllum tuberculatum (Forssk) A. Juss. J. Coast Life Med. 2016, 4, 315–319. [Google Scholar]
- Rex, J.H.; Pfaller, M.A.; Rinaldi, M.G.; Polak, A.; Galgiani, J.N. Antifungal susceptibility testing. Clin. Microbiol. Rev. 1993, 6, 367–381. [Google Scholar] [CrossRef]
- Singh, R.P.; Singh, P.K.; Rutkoski, J.; Hodson, D.P.; He, X.; Jørgensen, L.N.; Hovmøller, M.S.; Huerta-Espino, J. Disease impact on wheat yield potential and prospects of genetic control. Annu. Rev. Phytopathol. 2016, 54, 303–322. [Google Scholar] [CrossRef] [Green Version]
- Hof, H. Critical annotations to the use of azole antifungals for plant protection. Antimicrob. Agents Chemother. 2001, 45, 2987–2990. [Google Scholar] [CrossRef] [Green Version]
- Al-Hatmi, A.M.S.; van Diepeningen, A.D.; Curfs-Breuker, I.; de Hoog, G.S.; Meis, J.F. Specific antifungal susceptibility profiles of opportunists in the Fusarium fujikuroi complex. J. Antimicrob. Chemother. 2015, 70, 1068–1071. [Google Scholar] [CrossRef] [Green Version]
- Rex, J.H.; Rinaldi, M.G.; Pfaller, M.A. Resistance of Candida species to fluconazole. Antimicrob. Agents Chemother. 1995, 39, 1–8. [Google Scholar] [CrossRef] [Green Version]
- Sabry, O.M.; EI Sayed, A.M.; Sleem, A.A. Potential Anti-Microbial, Anti-Inflammatory and Anti-Oxidant Activities of Haplophyllum tuberculatum growing in Libya. J. Pharmacogn. Nat. Prod. 2016, 2, 116. [Google Scholar] [CrossRef] [Green Version]
- Debouba, M.; Khemakhem, B.; Zouari, S.; Meskine, A.; Gouia, H. Chemical and biological activities of Haplophyllum tuberculatum organic extracts and essential oil. J. Essent. Oil Bear. Plants 2014, 17, 787–796. [Google Scholar] [CrossRef]
- Jung, H.J.; Hwang, I.A.; Sung, W.S.; Kang, H.; Kang, B.S.; Seu, Y.B.; Lee, D.G. Fungicidal effect of resveratrol on human infectious fungi. Arch. Pharmacal Res. 2005, 28, 557–560. [Google Scholar] [CrossRef]
- Adrian, M.; Jeandet, P.; Veneau, J.; Weston, L.A.; Bessis, R. Biological activity of resveratrol, a stilbenic compound from grapevines, against Botrytis cinerea, the causal agent for gray mold. J. Chem. Ecol. 1997, 23, 1689–1702. [Google Scholar] [CrossRef]
- Paulo, L.; Ferreira, S.; Gallardo, E.; Queiroz, J.A.; Domingues, F. Antimicrobial activity and effects of resveratrol on human pathogenic bacteria. J. Microbiol. Biotechnol. 2010, 26, 1533–1538. [Google Scholar] [CrossRef]
- Shahriari, A.G.; Ghodoum Parizipour, M.H. Antiviral activity of aqueous extract of alligator plant, Bryophyllum daigremontianum L., against RNA and DNA plant viruses. J. Crop Prot. 2019, 8, 465–478. [Google Scholar]
- Hoegen, E.; Strömberg, A.; Pihlgren, U.; Kombrink, E. Primary structure and tissue-specific expression of the pathogenesis-related protein PR-1b in potato. Mol. Plant Pathol. 2002, 3, 329–345. [Google Scholar] [CrossRef]
- Vlot, A.C.; Dempsey, D.A.; Klessig, D.F. Salicylic acid, a multifaceted hormone to combat disease. Annu. Rev. Phytopathol. 2009, 47, 177–206. [Google Scholar] [CrossRef] [Green Version]
- Wang, R.; Wang, S.; Pan, W.; Li, Q.; Xia, Z.; Guan, E.; Zheng, M.; Pang, G.; Yang, Y.; Yi, Z. Strategy of tobacco plant against black shank and Tobacco mosaic virus infection via induction of PR-1, PR-4 and PR-5 proteins assisted by medicinal plant extracts. Physiol. Mol. Plant Pathol. 2018, 101, 127–145. [Google Scholar] [CrossRef]
- Kang, J.H.; McRoberts, J.; Shi, F.; Moreno, J.E.; Jones, A.D.; Howe, G.A. The flavonoid biosynthetic enzyme chalcone isomerase modulates terpenoid production in glandular trichomes of tomato. Plant Physiol. 2014, 164, 1161–1174. [Google Scholar] [CrossRef] [Green Version]
- Marais, J.P.J.; Deavours, B.; Dixon, R.A.; Ferreira, D. The stereochemistry of flavonoids. In The Science of Flavonoids; Grotewold, E., Ed.; Springer: Columbus, OH, USA, 2006. [Google Scholar]
- Tsao, R.; Marvin, C.H.; Broadbent, A.B.; Friesen, M.; Allen, W.R.; McGarvey, B.D. Evidence for an isobutylamide associated with host-plant resistance to western flower thrips, Frankliniella occidentalis, in chrysanthemum. J. Chem. Ecol. 2005, 31, 103–110. [Google Scholar] [CrossRef] [PubMed]
- Leiss, K.A.; Maltese, F.; Choi, Y.H.; Verpoorte, R.; Klinkhamer, P.G.L. Identification of chlorogenic acid as a resistance factor for thrips in chrysanthemum. Plant Physiol. 2009, 150, 1567–1575. [Google Scholar] [CrossRef] [PubMed] [Green Version]
- Abdelkhalek, A.; Dessoky, E.S.; Hafez, E. Polyphenolic genes expression pattern and their role in viral resistance in tomato plant infected with Tobacco mosaic virus. Biosci. Res. 2018, 15, 3349–3356. [Google Scholar]
- Niggeweg, R.; Michael, A.J.; Martin, C. Engineering plants with increased levels of the antioxidant chlorogenic acid. Nat. Biotechnol. 2004, 22, 746–754. [Google Scholar] [CrossRef] [PubMed]

| Primer Name | Abbreviation | Direction | Sequence (5′–3′) | References |
|---|---|---|---|---|
| Pathogenesis-related protein-1 | PR-1 | Forward | CCAAGACTATCTTGCGGTTC | [61] |
| Reverse | GAACCTAAGCCACGATACCA | |||
| Chalcone synthase | CHS | Forward | CACCGTGGAGGAGTATCGTAAGGC | [62] |
| Reverse | TGATCAACACAGTTGGAAGGCG | |||
| Hydroxycinnamoyl Co A quinate hydroxycinnamoyl transferase | HQT | Forward | CCCAATGGCTGGAAGATTAGCTA | [62] |
| Reverse | CATGAATCACTTTCAGCCTCAACAA | |||
| Beta-actin | β-actin | Forward | ATGCCATTCTCCGTCTTGACTTG | [63] |
| Reverse | GAGTTGTATGTAGTCTCGTGGATT | |||
| Tobacco mosaic virus-coat protein | TMV-CP | Forward | ACGACTGCCGAAACGTTAGA | [64] |
| Reverse | CAAGTTGCAGGACCAGAGGT |
| Compound | Amount (mg/kg) |
|---|---|
| Chlorogenic acid | ND |
| p-Coumaric acid | ND |
| Naringenin | ND |
| Pyrogallol | ND |
| Gallic acid | 8.35 |
| Ferulic acid | 26.86 |
| Catechin | 27.43 |
| Quinol | 33.85 |
| Syringic acid | 35.91 |
| Caffeic acid | 39.63 |
| Vanillic acid | 45.14 |
| Ellagic acid | 45.39 |
| Cinnamic acid | 46.79 |
| o-Coumaric acid | 81.22 |
| Catechol | 120.66 |
| Benzoic acid | 199.51 |
| p-Hydroxy benzoic acid | 221.47 |
| Rosmarinic acid | 387.33 |
| Quercetin | 401.04 |
| Rutin | 487.04 |
| Myricetin | 561.18 |
| kaempferol | 1735.23 |
| Resveratrol | 5178.58 |
| Treatment | Inhibition Percentage of Fungal Linear Growth (%) | |
|---|---|---|
| F. culmorum | R. solani | |
| H. tuberculatum WPE (1%) | 46.29d ± 0.37 * | 49.62c ± 0.37 |
| H. tuberculatum WPE (2%) | 72.96b ± 0.37 | 66.29b ± 0.37 |
| H. tuberculatum WPE (3%) | 82.96a ± 0.37 | 93.70a ± 0.37 |
| Fluconazole (25 µg) | 53.70c ± 0.37 | 42.96d ± 0.37 |
| Control (DMSO 10%) | 0.00e | 0.00e |
| LSD 0.05 | 1.04 | 1.04 |
© 2020 by the authors. Licensee MDPI, Basel, Switzerland. This article is an open access article distributed under the terms and conditions of the Creative Commons Attribution (CC BY) license (http://creativecommons.org/licenses/by/4.0/).
Share and Cite
Abdelkhalek, A.; Salem, M.Z.M.; Hafez, E.; Behiry, S.I.; Qari, S.H. The Phytochemical, Antifungal, and First Report of the Antiviral Properties of Egyptian Haplophyllum tuberculatum Extract. Biology 2020, 9, 248. https://doi.org/10.3390/biology9090248
Abdelkhalek A, Salem MZM, Hafez E, Behiry SI, Qari SH. The Phytochemical, Antifungal, and First Report of the Antiviral Properties of Egyptian Haplophyllum tuberculatum Extract. Biology. 2020; 9(9):248. https://doi.org/10.3390/biology9090248
Chicago/Turabian StyleAbdelkhalek, Ahmed, Mohamed Z. M. Salem, Elsayed Hafez, Said I. Behiry, and Sameer H. Qari. 2020. "The Phytochemical, Antifungal, and First Report of the Antiviral Properties of Egyptian Haplophyllum tuberculatum Extract" Biology 9, no. 9: 248. https://doi.org/10.3390/biology9090248
APA StyleAbdelkhalek, A., Salem, M. Z. M., Hafez, E., Behiry, S. I., & Qari, S. H. (2020). The Phytochemical, Antifungal, and First Report of the Antiviral Properties of Egyptian Haplophyllum tuberculatum Extract. Biology, 9(9), 248. https://doi.org/10.3390/biology9090248









